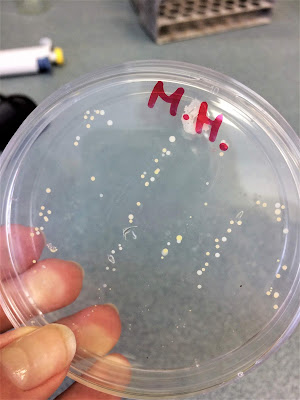

Jen pro začátek: Je mi jasný, že tohle téma moc lidí, hlavně v mém okolí, nezajímá. I přesto jsem se rozhodla článek napsat a sdílet s vámi tuhle zkušenost, protože něco takového nezažívám každý den. Sem tam jsem se ho snažila proložit informacemi, které by pro někoho mohly být nové. Navíc i kdyby se našel jen jeden člověk, kterému se článek bude líbit nebo se dozví něco zajímavého, stojí to za to.
A ještě jedna věc. Jména lidí, kteří s námi trávili čas, píšu celá, tzn. i s titulem – inženýr. A i když to o titulech samozřejmě není, přijde mi škoda ho vynechat, když na jeho získání makali tak dlouho. Jen si pod tím nutně nepředstavujte vyloženě drsný lidi nebo kravaťáky, jako já. (Nevím proč, od mala to mám takhle zafixované :D)
—
Na událost s názvem “Vědcem na vlastní kůži” jsem narazila na Facebooku a popravdě se hodně dlouho rozmýšlela, zda do toho jít či ne. Čekala jsem tak dlouho, až byla volná poslední dvě místa (z 15). Nechtěla jsem, aby to byla další promarněná šance, které jsem nevyužila. A že jich letos bylo. Řekla jsem si, že můžu přeci jen získat a když se mi to nebude to pravý ořechový, maximálně odjedu.
Proč jsem se přihlásila?
Bylo to svým způsobem vykročení z té mojí komfortní zóny, které jsem cítila, že potřebuju. Navíc pořád mluvím o tom, jak nechci jenom sedět doma a zažít něco nového.
Největší strach jsem měla z lidí, se kterými tam budu. Neznala jsem tam totiž vůbec nikoho. Bála jsem se i ubytování – jak to na koleji bude vypadat, s kým budu sdílet pokoj…prostě strach z neznáma. Ale víte co? Nakonec to dopadlo, jak nejlíp mohlo. Lidi skvělý, ubytování v pohodě…Teda až na první noc, to jsem spala na palandě bez zábrany, se sevřeným zadkem, abych v noci nespadla. Už jsem zmiňovala, že nesnáším palandy?
A jelikož jdu do třeťáku (je to možný, že ten čas tak letí?!), mám nejvyšší čas začít koukat po vysokých školách. Bylo by mnohem jednodušší, kdybych aspoň věděla obor a co bych jednou chtěla dělat. Ale i to je jeden z hlavních důvodů, proč jsem se přihlásila.
Vždycky, když se mě někdo zeptá “A už aspoň víš co?”, tak odpovídám “Noo, asi něco s biologií a chemií.”. Ale jistá si tím nejsem vůbec. Tudíž jsem si chtěla vyzkoušet, jestli by mě něco takového bavilo a co to vlastně obnáší.
K tomuhle odstavci se skvěle hodí článek – Čím teda chceš být, který jsem napsala v březnu. A díky němu jsem si zase uvědomila, jak ten vesmír funguje. Chtěla jsem se sebevzdělávat, získávat zkušenosti a hledat, co bych chtěla studovat, tak mi do cesty přišel tenhle kurz.
Náhoda? Nemyslím si. 🙂
Zemědělka? No to ani náhodou.
Když se řekne “zemědělka”, hodně lidí si představí totální odpad, nic moc úroveň, flákárnu, že to zvládne každý… I já mezi ně tak trochu patřila. Jsem proto ráda, že jsem měla možnost udělat si vlastní názor a byla jsem mile překvapená. Nejvíc asi z toho celého areálu. Všechno je pěkně propojené, krásný sportovní areál, který jsem dokonce jednou využila, protože mi cvičení začalo chybět. A byla to nádhera mít celý ovál jen por sebe, to vám povím. Pak samozřejmě menza, restaurace, hezké vybavení…a do centra to není vůbec daleko.
Jaký byl náš program?
Pondělí byla taková seznamovačka, jak už tomu obvykle bývá. Sešli jsme se na Fakultě agrobiologie, potravních a přírodních zdrojů, kde jsme každé ráno začínali.
První přednášku měl Ing. Martin Kulma, se kterým jsme se dozvěděli zajímavé informace o hmyzu, zahráli si hru hádej kdo a taky vyrazili poprvé do terénu, konkrétně do Lysolajského údolí. Cílem bylo vyzkoušet si chytání a monitoring motýlů, a také nachytání klíšťat pro pokus s repelentem. Takže pokud jste někdo viděl lidi co tam běhají se síťkou nebo bílou vlajkou, vsadím kalhoty, že jsme to byli my. 🙂
Na fakultě jsme potom zkoušeli účinnost přírodních vs. chemických repelentů, kde podle očekávání měly (bohužel) větší účinnost ty chemické.
Druhý den byl program v režii herpetologa Ing. Daniela Kolešky. Herpetolog je člověk zabývající se plazy a obojživelníky. Vzhledem k těm neskutečným vedrům jsme program otočili a nejprve vyrazili do terénu k Únětickému potoku. Slunné stráně nad potokem jsou přirozeným habitatem (prostředím) ještěrek, kvůli kterým jsme tam šli. Ale bohužel se nám je nepodařilo chytit, maximálně zahlédnout. Pěšky jsme proto přešli do Roztoků, odkud jsme se přesunuli autobusem a přívozem k Vltavě. Jo a přívozem jsem jela poprvé! Tam už jsme byli úspěšnější, protože se Lucce podařilo chytit dvě malinké užovky podplamaté. Poprvé jsem tak držela hada ve volné přírodě a byl to skvělý zážitek!
Ve středu přišla na řadu hydrobiologie s Ing. Miloslavem Petrtýlem, PhD. Podívali jsme se do místnosti s akvárii, ve kterých byli převážně raci, ale také škeble. Věděli jste, že škeble má schopnost filtrovat vodu? Pro mě to byla zajímavá novinka. Nicméně ani tentokrát jsme neseděli pouze v učebnách, takže po přednášce jsme se vydali opět k Únětickému potoku. Tentokrát jsme vyfasovali cedníky s pinzetou a lovili bezobratlé.
Kdybyste mi ještě nedávno řekli, že budu muset (byť v holinkách, který jsem měla naposledy na táboře) stát v brčále, hrabat pod vodou cedníkem a vybírat z hlíny potvůrky, asi bych se vám vysmála. Ale víte co? Mně to vlastně přišlo zajímavý!
 Ve středu jsme se taky s holkama konečně rozhodly vyrazit do víru velkoměsta a projít si centrum. Nakonec to byl Václavák, kde jsme po pár minutách zapluly do krásnýho knihkupectví. Pak přišlo na řadu pár obchodů, Hamleys, dále povídání s Korejcem, který skvěle zpíval u Palladia, zastavení se u malého stánku s ručně tkanými výrobky, kde si Anička koupila nádhernou šálu…prostě skvělý odpoledne. Zakončily jsme ho skvělou večeří v Thai Thai & Ramen, poslaly pohledy a kolem jedenáctý se vrátily na kolej.
Ve středu jsme se taky s holkama konečně rozhodly vyrazit do víru velkoměsta a projít si centrum. Nakonec to byl Václavák, kde jsme po pár minutách zapluly do krásnýho knihkupectví. Pak přišlo na řadu pár obchodů, Hamleys, dále povídání s Korejcem, který skvěle zpíval u Palladia, zastavení se u malého stánku s ručně tkanými výrobky, kde si Anička koupila nádhernou šálu…prostě skvělý odpoledne. Zakončily jsme ho skvělou večeří v Thai Thai & Ramen, poslaly pohledy a kolem jedenáctý se vrátily na kolej.
Čtvrtek byl opět ve znamení hydrobilogie, ale tentokrát jsme po předchozích dnech strávených venku zůstali na fakultě. Třídili jsme ryby na sladkovodní a mořské, snažili hádat názvy…A v průběhu toho všecho jsme na ně museli sahat, vytahovat je z nálevu, hledat co je na nich zvláštní…Chvíli mi trvalo, než jsem si na to zvykla, protože vidět takhle mrtvý rybičky není nic moc pro mě.
Následně jsme přečetli dva články ohledně nebezpečí těžkých kovů a hráli jednu hru, přesněji na ančovičky, tuňáky a loď, ve který jsem moc neviděla smysl. Ale když nám pak ukázali, co se za tím skrývalo, všechno začalo dávat smysl. Ve stručnosti šlo o to, že když sníte ančovičku, nebezpečí zdravotních potíží kvůli těžkým kovům je minimální. Ale když těch několik desítek ančoviček sní tuňák a tuňáka sní nějaká větší ryba, zavání to průšvihem. V té rybě bude totiž nahromaděný všechen ten těžký kov, který do sebe omylem ostatní ryby dostali. A když člověk sní maso z takovéhle větší ryby, riziko je o dost větší. Tím neříkám, že když sníte jednou za dva týdny rybu, budete mít otravu těžkými kovy. Jen mi přijde zajímavé si uvědomit, jak potravní řetězec funguje v obou směrech.
Poslední den přišla na řadu mikrobiologie s Ing. Romanem Švejstilem. Většinu dne jsme strávili v laboratoři a zkoumali bakterie. Ty jsme získali stěrem z ruky, který jsme udělali už ve středu a natřeli ho do připraveného gelu v Petriho misce. A tohle v ní do pátku vyrostlo.(viz obrázek)
Poslední den přišla na řadu mikrobiologie s Ing. Romanem Švejstilem. Většinu dne jsme strávili v laboratoři a zkoumali bakterie. Ty jsme získali stěrem z ruky, který jsme udělali už ve středu a natřeli ho do připraveného gelu v Petriho misce. A tohle v ní do pátku vyrostlo.(viz obrázek)
Kdybych vám tu popisovala celý proces, stejně to většině z vás nic neřekne, takže to zkrátím. Bakterie jsme natřeli na sklíčko, usušili a zafixovali nad kahanem, nalili na to fialovou barvu, opláchli a zase usušili nad plamenem. Výsledek jsme dali pod mikroskop, kde jsme mohli vidět tyčinky, koky (kolečka) nebo jiné tvary.
Spoustu věcí pro mě byla novinka a zajímavá zkušenost.
Taky jsem poprvé jsem pracovala s pořádnou pipetou, viděla centrifugu v akci, výsledky nám zpracovala “mašina” za 10 milionů…jak říkám, spousta zkušeností, které se jen tak nenaskytnou.
Co mi to dalo?
Jsem moc ráda za možnost vidět Českou zemědělskou univerzitu zevnitř a udělat si na ní vlastní názor.
V dnešní době je hrozně jednoduchý přejímat názory ostatních, s čímž mám sama občas problém. A věřte mi, je to úplně něco jiného, když tam strávíte pět dní i s přenocováním na koleji, než když půjdete na den otevřených dveří. Ale i na ten si určitě zajděte 🙂
Další velké plus – mohli jsme se kdykoliv na cokoliv zeptat. Mě nejvíc zajímalo, jak to tam chodí, jak je studium náročný a třeba srovnání s UK. Navíc hrozně cením, že k nám byli všichni upřímní. A díky tomu třeba vím, že kdybych se náhodou rozhodla studovat vyloženě chemii, mám jít radši na VŠCHT. (Vysoká škola chemicko-technologická)
V neposlední řadě, jak jsem již zmiňovala skrz celý článek, jsem se dozvěděla spoustu nových informací, vyzkoušela si práci v laboratoři i terénu… A určitě už nezapomenu, co je to malakologie. 🙂 (nauka o měkkýších)
Moc vděčná jsem taky za holky, který jsem tam potkala. Konečně jsem měla pocit, že mi někdo rozumí. Naše názory se shodovaly v tolika věcech, že jsem si říkala, jestli je to vůbec možný. Konečně jsem našla někoho, kdo taky se snaží vyhýbat plastu, snaží se žít zero waste (k čemuž mám zatím daleko), používají vesměs přírodní kosmetiku…A musela jsem se v duchu pousmát, když jsme společně nakupovaly a každá vytáhla plátěnku :).
Šla bych do toho znova?
Jednoznačně ANO!
Tímhle článkem bych ještě jednou chtěla poděkovat všem, kteří se na této skvělé akci podíleli. Všem doktorandům, účastníkům, ale zejména Ing. Lucce Bohaté, která tam s námi byla každý den a většinu programu zařizovala ona. Díky, Luci!
Děkuju všem kteří to dočetli až sem, mějte se krásně a budu ráda za jakoukoliv zpětnou vazbu :).














